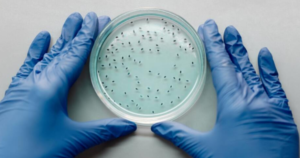

La Organización Mundial de la Salud (OMS) ya tiene en la mira una nueva enfermedad que podría provocar una pandemia más letal que el Covid-19. Se trata de ‘Disease X’ y a continuación te explicamos por qué representa una amenaza para la salud global.
De acuerdo con su página oficial, la OMS tiene programas de inversión, investigación y desarrollo de vacunas así como pruebas de detección y tratamientos para la prevención de enfermedades que puedan poner en riesgo la salud de la humanidad, como ‘Disease X’, un concepto que ha invadido las redes sociales en los últimos días.
¿Qué es Disease X y por qué es peligrosa?
‘Disease X’ es un concepto incluido por la OMS en la lista de enfermedades prioritarias de 2018. Es empleado para referirse a una enfermedad desconocida (X) de potencial pandémico, similar al del virus de Covid-19, con la finalidad de formalizar sus esfuerzos en la identificación de virus peligrosos y la prevención en recursos.
En total el organismo de gobierno engloba nueve enfermedades consideradas como de atención prioritaria por los estragos que podrían causar en la población. Dentro del listado se encuentran:
- Covid-19
- Fiebre hemorrágica de Crimea-Congo
- Enfermedad por el virus del Ébola y enfermedad por el virus de Marburg
- fiebre de Lassa
- Síndrome respiratorio de Oriente Medio coronavirus (MERS-CoV) y Síndrome Respiratorio Agudo Severo (SARS)
- Nipah y enfermedades henipavirales
- Fiebre del Valle del Rift
- zika
- “Enfermedad X” *
Cabe destacar que esta no es una lista exhaustiva, ni indica las causas más probables de la próxima epidemia, es únicamente de material preventivo que ayuda a la organización de posibles epidemias mundiales, por lo que constantemente se revisa y actualiza esta lista a medida que surgen las necesidades y cambian las metodologías.
¿Qué dice la OMS de Disease X?
Aunque hasta ahora ‘Disease X’ tal y como su nombre lo indica es una enfermedad desconocida, el concepto ayuda a la OMS a representar el conocimiento de que una epidemia internacional grave podría ser causada por un patógeno que actualmente se desconoce.
Ante un posible ‘Disease X’, el organismo de gobierno tiene trazado el Plan de I+D, que busca explícitamente permitir una preparación temprana e transversal para la enfermedad desconocida que ponga en riesgo la salud global.